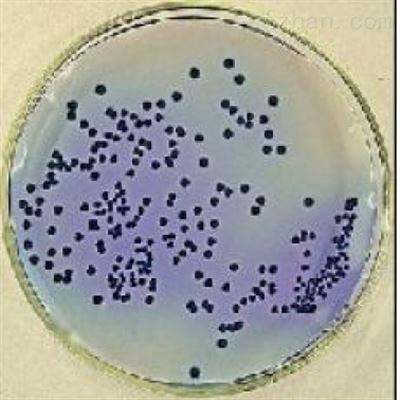
琼脂糖电泳试剂盒

相关产品推荐更多 >
万千商家帮你免费找货
0 人在求购买到急需产品
- 详细信息
- 文献和实验
- 技术资料
- 应用:
科研
- 检测方法:
酶联检测
- 供应商:
上海一研
- 规格:
详见说明书
➷将具有专一性的抗体固著于塑胶孔盘上,完成后洗去多余抗体;➷
➷➷加入待测检体,检体中若含有待测的抗原,则其会与塑胶孔盘上的抗体进行专一性键结;➷
➷洗去多余待测检体,加入另一种对抗原专一的一次抗体,与待测抗原进行键结;➷
➷➷洗去多余未键结一次抗体,加入带有酶的二次抗体,与一次抗体键结;➷
➷洗去多余未键结二次抗体,加入酶底物使酵素呈色,以肉眼或仪器读取呈色结果;➷
※★※间接法,一般的操作步骤为:
➷➷将已知的抗原固著于塑胶孔盘上,完成后洗去多余的抗原。➷
➷加入待测检体,检体中若含有待测的一次抗体,则其会与塑胶孔盘上的抗原进行专一性键结。➷
➷➷洗去多余待测检体,加入带有酶的二次抗体,与待测的一次抗体键结。➷
➷洗去多余未键结二次抗体,加入酶底物使酶呈色,藉仪器测定塑胶盘中的吸光值,以评估有色终产物的含量即可测量待测抗体的含量。➷
※★※竞争法,其操作步骤为:
➷➷将具有专一性的抗体固著于塑胶孔盘上,完成后洗去多余抗体➷
➷加入待测检体,使检体中的待测抗原与塑胶孔盘上的抗体进行专一性键结➷
➷➷加入带有酶的抗原,此抗原也可与塑胶孔盘上的抗体进行专一性键结,由于塑胶孔盘上固著的抗体数量有限,因此当检体中抗原的量越多,则带有酶的抗原可键结的固著抗体就越少,亦即,两种抗原皆竞相与塑胶孔盘上抗体键结,即所谓竞争法之由来。➷
➷➷洗去检体与带有酶的抗原,加入酶底物使酶呈色,当检体中抗原量越多,代表塑胶孔盘内留下之带有酶的抗原越少,显色也就越浅。➷
人肠脂肪酸结合蛋白(iFABP)ELISA试剂盒 英文名称:Human intestinal fatty acid binding protein,iFABP ELISA Kit 规格:96T/48T
人内吗肽-2(EM-2)ELISA试剂盒 英文名称:Human endomorphin-2,EM-2 ELISA Kit 规格:96T/48T
兔子基质金属蛋白酶9(MMP-9)ELISA试剂盒 英文名称:rabbit matrix metalloproteinase 9,MMP-9 ELISA Kit 规格:96T/48T
猪免疫球蛋白M(IgM)ELISA试剂盒 英文名称:Porcine Immunoglobulin M,IgM ELISA Kit 规格:96T/48T
大鼠血管内皮细胞生长因子C(VEGF-C)ELISA试剂盒 英文名称:Rat Vascular Endothelial cell Growth Factor C,VEGF-C ELISA Kit 规格:96T/48T
大鼠超氧化物歧化酶(SOD)ELISA试剂盒 英文名称:Rat Super Oxidase Dimutase,SOD ELISA Kit 规格:96T/48T
小鼠白介素1β (IL-1β)ELISA试剂盒 英文名称:Mouse Interleukin 1β,IL-1β ELISA Kit 规格:96T/48T
小鼠血浆α颗粒膜蛋白(GMP-140)ELISA试剂盒 英文名称:Mouse alpha-granular membrane protein,GMP-140 ELISA Kit 规格:96T/48T
人杀菌性/通透性增加蛋白(BPI)ELISA试剂盒 英文名称:Human bactericidal/permeabilityincreasingprotein,BPI ELISA Kit 规格:96T/48T
人基质裂解素(ST2)ELISA试剂盒 英文名称:Human Stromelysin-2,ST2 ELISA Kit 规格:96T/48T
人T细胞特异性鸟苷三磷酸酶(Tgtp)ELISA试剂盒 英文名称:Human T-cell specific GTPase,Tgtp ELISA Kit 规格:96T/48T
人抗表皮细胞基底膜抗体(EBMZ)ELISA试剂盒 英文名称:Human epidermal basement membrane zone,EBMZ ELISA Kit 规格:96T/48T
人甲状腺球蛋白(TG)ELISA试剂盒 英文名称:Human Thyroglobulin,TG ELISA Kit 规格:96T/48T
*泊苷 英文名称:Etoposide 规格:100mg 保存:-20℃,避光
吡拉西坦 英文名称:Laci Staw 规格:100mg 保存:-20℃,避光
大蒜素 英文名称:Allicin 规格:0.5ml 保存:-20℃,避光
肾上腺色腙 英文名称:Carbazochrome 规格:50mg 保存:-20℃,避光
氨力农 英文名称:An Linong 规格:100mg 保存:-20℃,避光
盐酸特拉唑嗪 英文名称:Terazosin hydrochloride 规格:100mg 保存:-20℃,避光
夫拉扎勃(原:呋咱甲氢龙) 英文名称:J La Szabo (formerly: furazabol) 规格:50mg 保存:-20℃,避光
豆腐果苷 英文名称:Helicid 规格:100mg 保存:-20℃,避光
琼脂糖电泳试剂盒紫杉醇 英文名称:Paclitaxel 规格:30mg 保存:-20℃,避光
更昔洛韦 英文名称:Ganciclovir 规格:100mg 保存:-20℃,避光
氯钠 英文名称:Sodium chloride 规格:100mg 保存:-20℃,避光
苯磺酸氨氯地平 英文名称:Amlodipine besylate 规格:100mg 保存:-20℃,避光
阿苯达唑 英文名称:Albendazole 规格:100mg 保存:-20℃,避光
风险提示:丁香通仅作为第三方平台,为商家信息发布提供平台空间。用户咨询产品时请注意保护个人信息及财产安全,合理判断,谨慎选购商品,商家和用户对交易行为负责。对于医疗器械类产品,请先查证核实企业经营资质和医疗器械产品注册证情况。
文献和实验做生物实验的人对琼脂和琼脂糖一定都不会陌生。不过要让你说出它们两者的区别,我想不少人都会支支吾吾。反正不一样呗,培养基用的是琼脂粉,电泳用的是琼脂糖。具体有啥学问,听我一一道来。 先来说说琼脂,它的英文名为agar。这个词来源于马来语的agar-agar,意思是胶状物。中国人亦称为洋菜或冻粉。日本人称之为寒天(kanten),因为它在冬天收获。台湾人叫它菜燕,和燕窝的质感差不多。韩国人的叫法是한
的影响,所以回收率并非是一成不变的。所以Qiagen以严谨的态度提供多种条件下的详细介绍:使用QIAquick回收之前和回收之后再混合的DNA 片段 (大小已指出) 。对所有尺寸的片段均获得了接近80%的回收率。A 1-5 : 回收之前; P : 回收之后再混合。样品使用 1.5% 琼脂糖凝胶分析(TAE buffer)。B 1-3: 回收之前; P : 回收之后混合。样品于 3.5% 高分辨琼脂糖凝胶上分析( TAE buffer)。M : pTZ-HinfI marker。记得《分子克隆II
相关专题 重组DNA技术工具酶 限制性内切酶可特异性的识别DNA序列上特定的核苷酸序列位点,一般购买限制性内切酶说明书上都会有一定的反应体系,酶切体系在一定温度放置一定时间后,需要进行DNA琼脂 糖电泳验证或者回收酶切效果。 实验原理 1、DNA的限制性酶切 限制性内切酶 特异性地结合于一段被称为限制酶识别序列的特殊DNA序列之内或其附近的特异位点上,并在此处切割双链DNA。它可分为3类。I类
技术资料暂无技术资料 索取技术资料